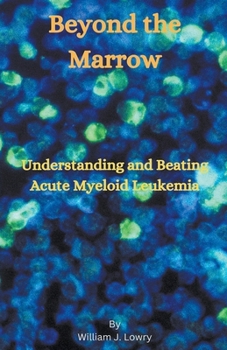
Paperback Beyond the Marrow Book

Beyond the Marrow
"Beyond the Marrow: Understanding and Beating Acute Myeloid Leukemia" is a comprehensive and compassionate guide that delves into the intricate landscape of Acute Myeloid Leukemia (AML). Written with both patients and their families in mind, this book offers a thorough exploration of AML, from its underlying biology and diagnosis to the latest advancements in treatment.
Readers will embark on a journey through the medical intricacies of AML, demystifying complex concepts and providing clarity on genetic mutations, risk factors, and the evolving landscape of therapeutic options. The book combines accessible explanations with the latest scientific knowledge, empowering individuals to make informed decisions about their care.
Interwoven with the science is the human side of the AML experience. Personal stories of resilience and triumph over AML serve as beacons of hope, illustrating that a diagnosis is not the end but the beginning of a fight that can be won.
"Beyond the Marrow" extends its reach beyond medical insights, addressing the emotional and practical aspects of the AML journey. From coping strategies and psychosocial support to practical advice on navigating treatment, this book is a holistic resource for those facing AML.
Informed by the latest research and international collaborations, "Beyond the Marrow" is a guide, companion, and source of inspiration for anyone touched by AML. It is a testament to the strength of the human spirit and the collective efforts to overcome the challenges posed by Acute Myeloid Leukemia.